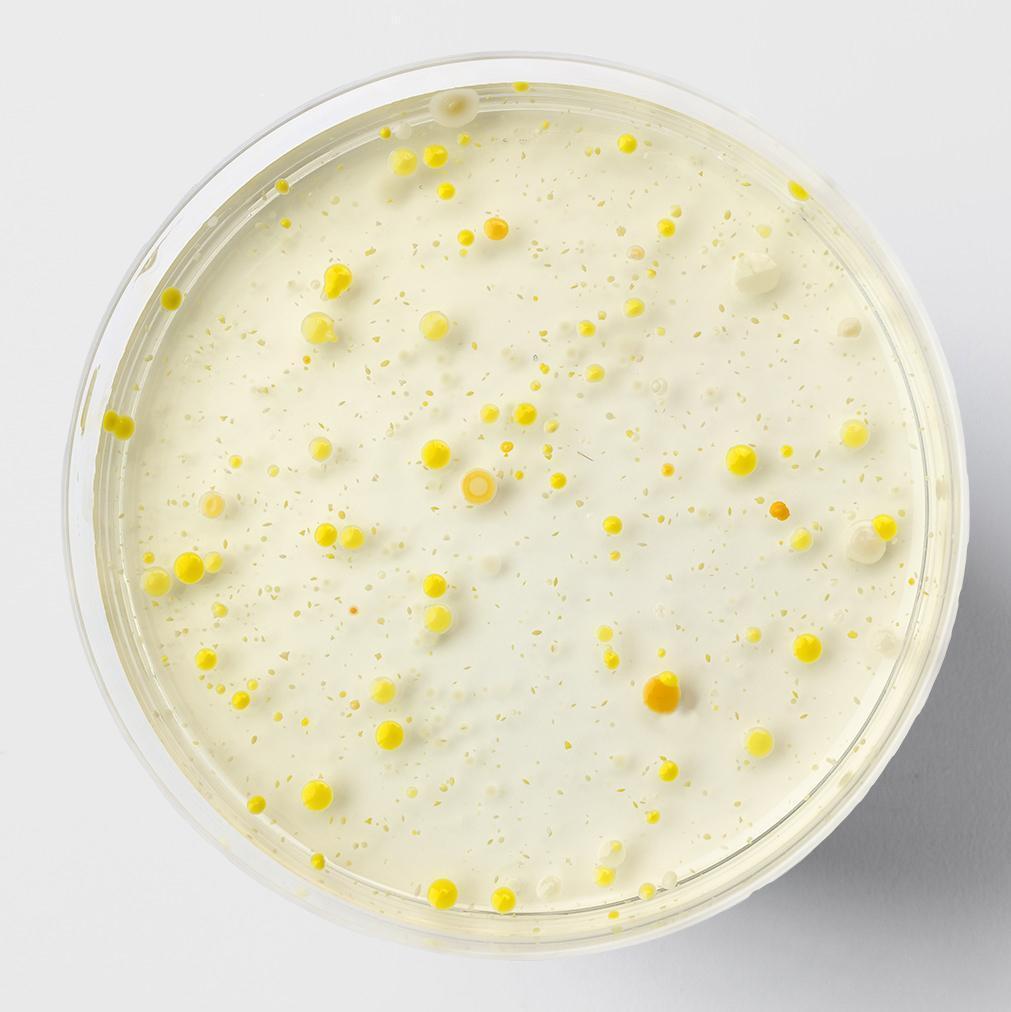
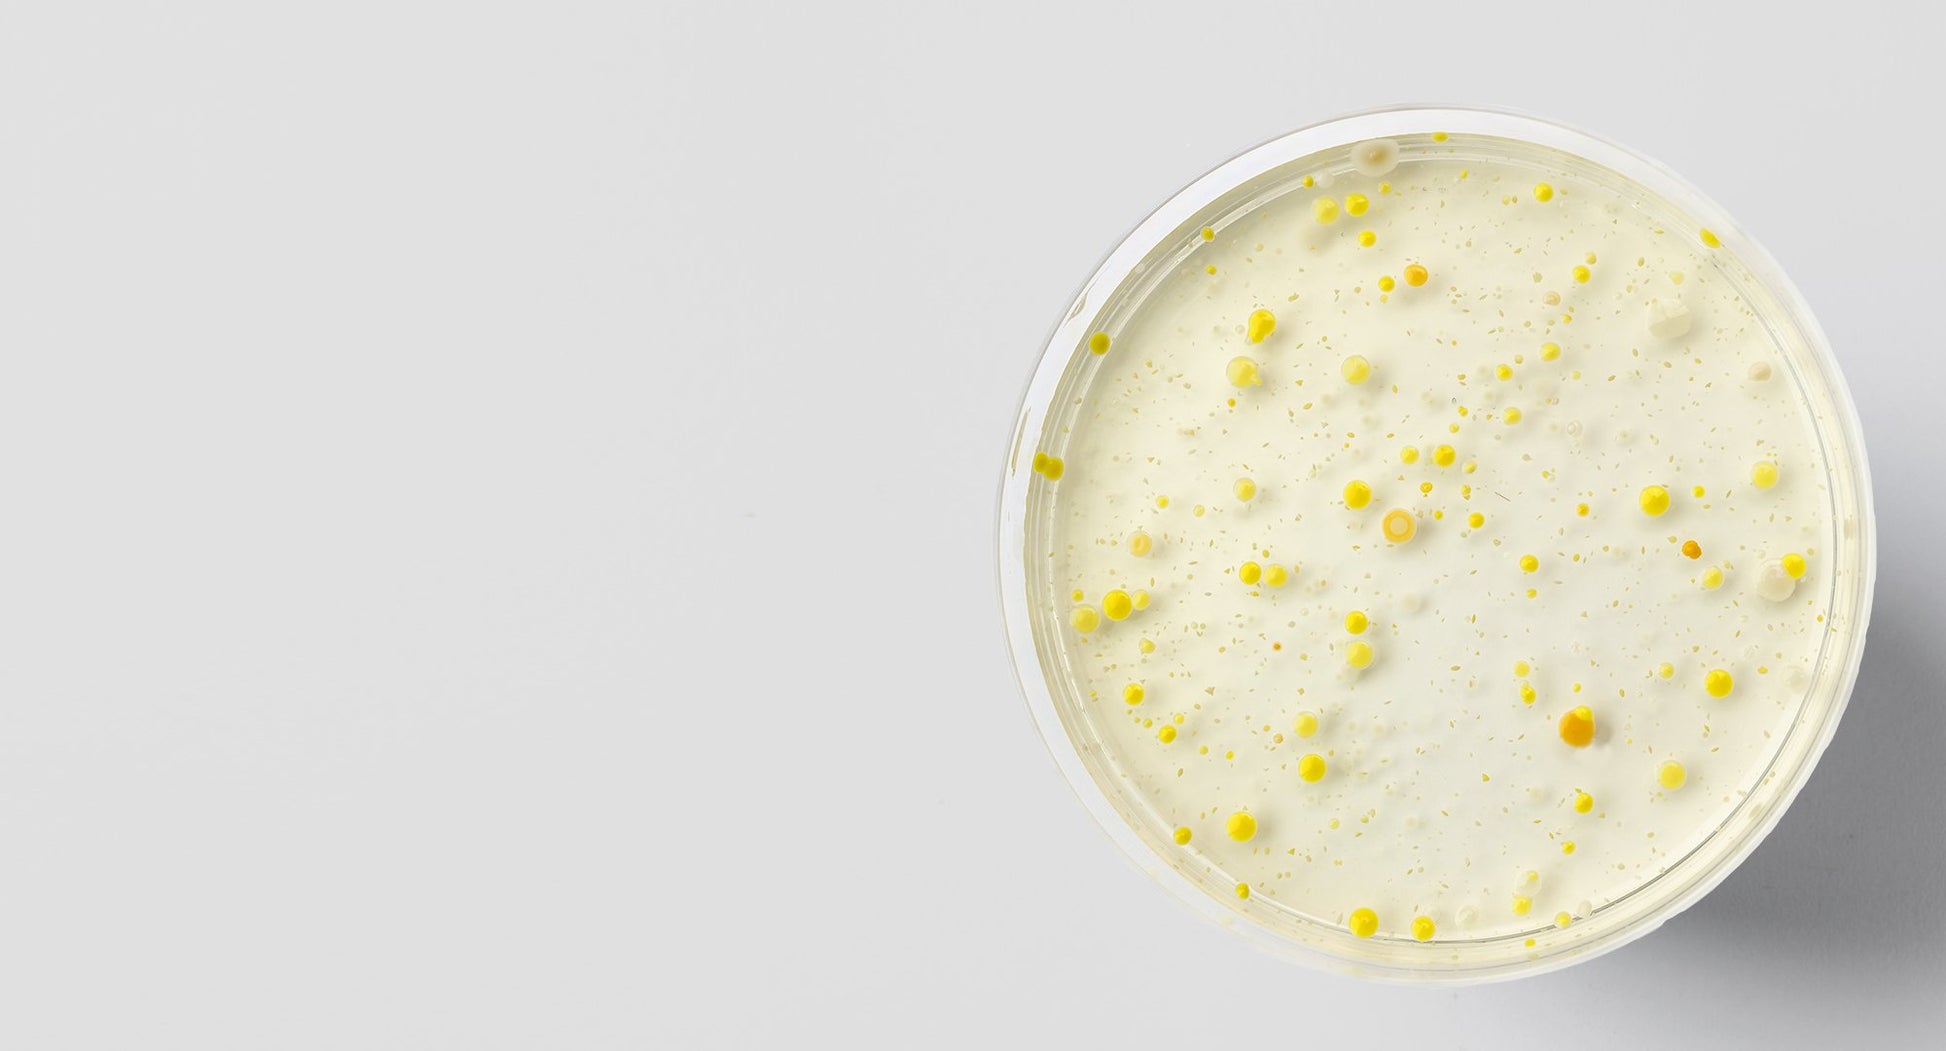

1
/
of
5
Nourished US
Bacillus coagulans MTCC5856 Probiotic
Bacillus coagulans MTCC5856 Probiotic
Regular price
$0.00 USD
Regular price
Sale price
$0.00 USD
Taxes included.
Quantity
Couldn't load pickup availability
Bacillus coagulans MTCC5856 is a live bacterium probiotic, and studies show several potential health benefits, including how it may support healthy weight and metabolic health when combined with a healthy lifestyle. This impressive ingredient has also been shown in clinical trials to support immune system.
Share